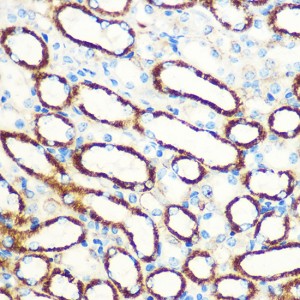
KO-Validated SAV1 Rabbit pAb (20 μl)

| Reactivity: | Human, Mouse, Rat |
| Applications: | WB, IHC, ELISA |
| Host Species: | Rabbit |
| Isotype: | IgG |
| Clonality: | Polyclonal antibody |
| Gene Name: | salvador family WW domain containing protein 1 |
| Gene Symbol: | SAV1 |
| Synonyms: | SAV; WW45; WWP4; V1 |
| Gene ID: | 60485 |
| UniProt ID: | Q9H4B6 |
| Immunogen: | Recombinant fusion protein containing a sequence corresponding to amino acids 199-383 of human SAV1 (NP_068590.1). |
| Dilution: | WB 1:500-1:2000; IHC 1:50-1:200 |
| Purification Method: | Affinity purification |
| Concentration: | 1.67 mg/mL |
| Buffer: | PBS with 0.05% proclin300, 50% glycerol, pH7.3. |
| Storage: | Store at -20°C. Avoid freeze / thaw cycles. |
| Documents: | Manual-SAV1 polyclonal antibody |
Background
WW domain-containing proteins are found in all eukaryotes and play an important role in the regulation of a wide variety of cellular functions such as protein degradation, transcription, and RNA splicing. The gene SAV1 encodes a protein with two WW domains, a SARAH domain, and a coiled-coil region and is ubiquitously expressed in adult tissues. This protein binds to MST1 (mammalian sterile 20-like kinase 1) and promotes MST1-induced apoptosis. It has also been shown to bind to HAX1 (hematopoietic cell-specific protein 1 (HS1)-associated protein X-1) and to attenuate the anti-apoptotic effects of HAX1. Studies in human and mouse suggest this gene acts as a tumor suppressor.
Images
 | Western blot analysis of lysates from wild type (WT) and SAV1 knockout (KO) HeLa cells, using [KO Validated] SAV1 Rabbit pAb (A18667) at 1:1000 dilution. Secondary antibody: HRP-conjugated Goat anti-Rabbit IgG (H+L) (AS014) at 1:10000 dilution. Lysates/proteins: 25μg per lane. Blocking buffer: 3% nonfat dry milk in TBST. Detection: ECL Basic Kit (RM00020). Exposure time: 90s. |
 | Western blot analysis of lysates from wild type (WT) and SAV1 knockout (KO) HeLa(KO) cells, using SAV1 Rabbit pAb (A18667) at 1:1000 dilution. Secondary antibody: HRP-conjugated Goat anti-Rabbit IgG (H+L) (AS014) at 1:10000 dilution. Lysates/proteins: 25ug per lane. Blocking buffer: 3% nonfat dry milk in TBST. Detection: ECL Basic Kit (RM00020). Exposure time: 50s. |
 | Immunohistochemistry analysis of paraffin-embedded Mouse kidney using [KO Validated] SAV1 Rabbit pAb (A18667) at dilution of 1:100 (40x lens). Microwave antigen retrieval performed with 0.01M PBS Buffer (pH 7.2) prior to IHC staining. |
 | Immunohistochemistry analysis of paraffin-embedded Rat kidney using [KO Validated] SAV1 Rabbit pAb (A18667) at dilution of 1:100 (40x lens). Microwave antigen retrieval performed with 0.01M PBS Buffer (pH 7.2) prior to IHC staining. |
 | Immunohistochemistry analysis of paraffin-embedded Human colon using [KO Validated] SAV1 Rabbit pAb (A18667) at dilution of 1:100 (40x lens). Microwave antigen retrieval performed with 0.01M PBS Buffer (pH 7.2) prior to IHC staining. |
You may also be interested in: